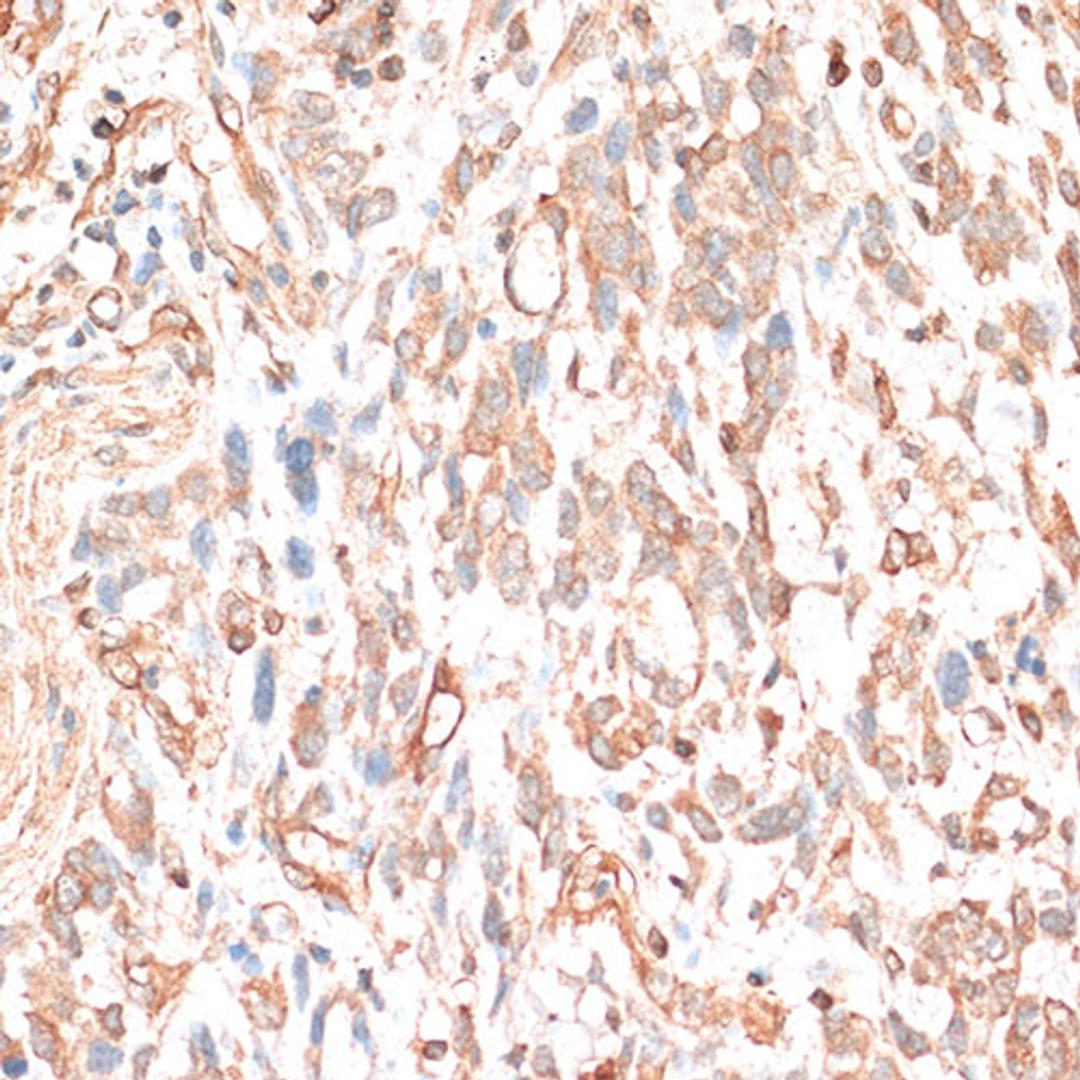
Immunohistochemistry - CDH11 antibody (A14717)

CDH11 Rabbit pAb
Product Details
- Cat. No.
- A14717
- Type
- Primary Antibody
- Clonality
- Polyclonal
- Host
- Rabbit

The supplier does not provide quotations for this antibody through SelectScience. You can search for similar antibodies in our Antibody Directory.
Description
This gene encodes a type II classical cadherin from the cadherin superfamily, integral membrane proteins that mediate calcium-dependent cell-cell adhesion. Mature cadherin proteins are composed of a large N-terminal extracellular domain, a single membrane-spanning domain, and a small, highly conserved C-terminal cytoplasmic domain. Type II (atypical) cadherins are defined based on their lack of a HAV cell adhesion recognition sequence specific to type I cadherins. Expression of this particular cadherin in osteoblastic cell lines, and its upregulation during differentiation, suggests a specific function in bone development and maintenance.
Biological Information
- Clonality: Polyclonal
- Host: Rabbit
- Reactivity: Human, Rat